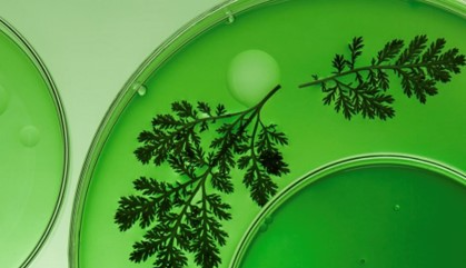

卓越的科研能力持續(xù)賦能品牌的革新與升級
驅(qū)動可持續(xù)增長
研發(fā)中心
研發(fā)團隊
研發(fā)歷史
基礎(chǔ)研究
基礎(chǔ)研究成果

活膚因(Tiracle Pro)

環(huán)六肽-9

E-AGSE葡萄籽提取物
中國上海團隊
中國上海團隊
海外團隊